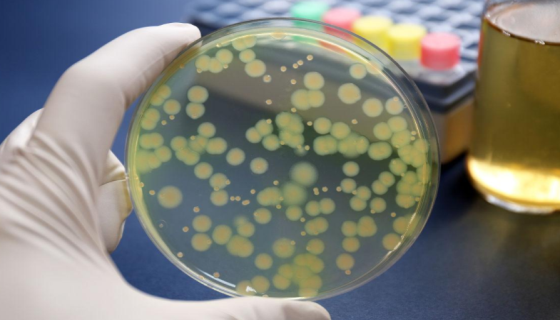
浅绿黄假单胞菌的形态特征及培养与保存方法！
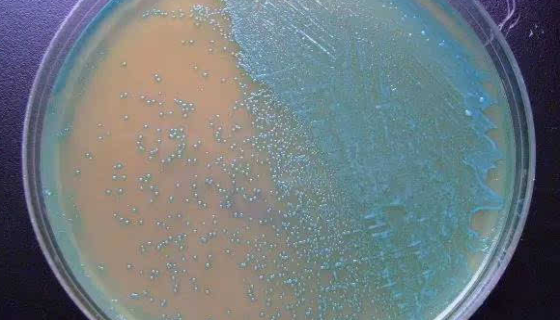
ATCC 27013 杀鲑气单胞菌日本鲑亚种

CP70人卵巢癌细胞的培养操作步骤及注意事项!
人卵巢癌细胞接收后的处理方法与培养步骤及注意事项有哪些?

红法夫酵母的培养方法及单层冻干管打管说明!
红法夫酵母是Phaffia属的微生物,原产地为中国。通过NT...

DMS 53人肺癌细胞收到后的处理方法与培养步骤!
人肺癌细胞仅用于科学研究或者工业应用等非医疗目的不可用于人类...

变色栓菌(云芝)——分解木质素和蛋白酶
变色栓菌的储存与培养及注意事项有哪些?

菠萝泛菌——用于筛选抗癌抗菌物质代用模型
菠萝泛菌是Pantoea属的微生物,原产地为中国。菌落大而平...
浅绿黄假单胞菌的形态特征及培养与保存方法!
浅绿黄假单胞菌是Pseudomonas属的微生物,原产地为英...

寒冷杆菌属的特点与优势及培养与保存方法!
寒冷杆菌属是Frigoribacterium属的微生物,原产...

HUCEC人正常宫颈上皮细胞常规培养操作流程!
人正常宫颈上皮细胞仅用于科研工作,未经许可不得用于其他目的,...
ATCC 27013 杀鲑气单胞菌日本鲑亚种
杀鲑气单胞菌日本鲑亚种是Aeromonas属的微生物,原产地...